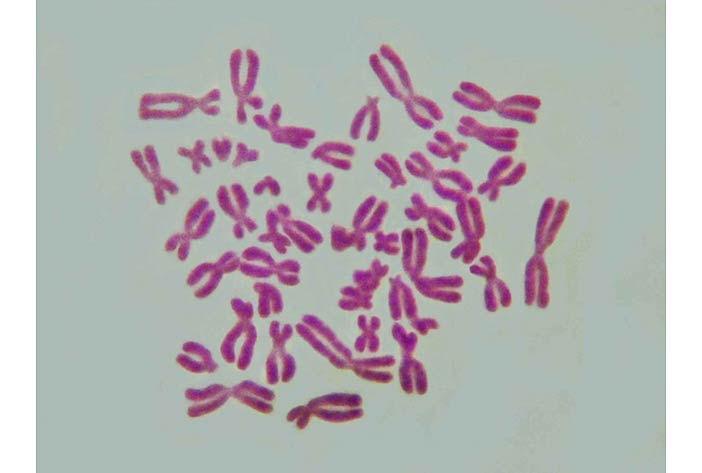

Học Sinh học, các bạn được dạy rằng bộ mã di truyền của chúng ta gồm phân tử ADN quấn quanh protein tạo thành cấu trúc gọi là nhiễm sắc thể. Nhiễm sắc thể chia ra thành nhiều đoạn, mỗi đoạn chứa thông tin di truyền (ví dụ: mắt xanh, tóc đen, vân vân) thì được gọi là gien. Nhiều bạn học chỉ biết nhiễm sắc thể gọi là vậy, chứ không hiểu vì sao lại có cái tên này.
Cấu trúc xoắn của ADN. Đây là hình vẽ bằng máy tính, nhằm mục đích minh họa, chứ phân tử ADN không chỉ xoắn đơn giản như vậy là thành nhiễm sắc thể. Thực tế, ADN xoắn tít, từ chuỗi xoắn kép nó quấn quanh protein, rồi lại tiếp tục xoắn thành cuốn rất chặt 2 lần mới thành nhiễm sắc thể.
Đây là một từ Hán-Việt. Nhiễm có nghĩa là nhuộm, nhuốm, dính phải, lây phải. Chữ “nhuộm/nhuốm” vốn là âm cổ hơn của chữ Hán-Việt này, nhưng giờ đã được Nôm hóa và dùng như từ Nôm. Sắc thì có nghĩa là màu. Nhiễm sắc thể là thể nhuộm màu.
Vì sao gọi là thể nhuộm màu? Vốn là ngày xưa, cách đây hơn trăm năm, kính hiển vi vẫn còn khá thô sơ. Để quan sát được nhiễm sắc thể lấy ra từ tế bào, người ta phải nhuộm màu cho nó. May mà nhiễm sắc thể rất dễ ăn màu từ thuốc nhuộm. Khi mới nghiên cứu nhiễm sắc thể, người ta chưa biết chức năng của cấu trúc này là gì, nên nhà sinh học người Đức von Waldeyer-Hartz đã gọi nó nôm na là thể nhuộm (được) màu.
Hình chụp qua kính hiển vi một tế bào cây thong cho thấy bộ nhiễm sắc thể gồm 12 đôi. Nhiễm sắc thể ở đây có màu xanh đậm sau khi được nhuộm và thuốc nhuộm bám vào ADN. Những điểm có màu xanh lá cây và đỏ là đánh dấu những đoạn ADN đặc hiệu ở các vùng khác nhau trong mỗi cặp nhiễm sắc thể, giúp nhận ra được cặp nào với cặp nào. (Ảnh của Dr. Nurul Faridi, từ trang này)
Với chữ nhiễm: chữ nhiễm Hán-Việt hiện giờ vẫn còn được dùng rất nhiều, thậm chí chính nó còn trở thành một động từ Nôm hóa, trong khi các biến âm cổ hơn của nó như nhuộm/nhuốm đã Nôm hóa hoàn toàn. Một số chữ:
- ô nhiễm: nhuộm bẩn, nhiễm bẩn.
- truyền nhiễm: lây truyền.
- tiêm nhiễm: bị lây, bị nhuốm dần dần. Tiêm (hay tiệm) có nghĩa là dần dần, từ từ, ví dụ: tiệm tiến, tiệm cận.
Trong tiếng Tây, nhiễm sắc thể được gọi là chromosom (Đức), hay chromosome (Anh/Pháp), với hai gốc Hy Lạp là chroma nghĩa là màu sắc và soma nghĩa là thể (cấu trúc). Gốc chromađược dùng khá nhiều trong tiếng Anh, nhất là trong khoa học kỹ thuật. Có một kim loại tên là chromium mà tiếng Việt chúng ta gọi là crôm. Nó có cái tên crôm đầy màu sắc là bởi vì crôm tạo rất nhiều muối và phức chất có màu rất đậm và sặc sỡ, từ vàng, tím, xanh, đỏ. Khi crôm lẫn vào cấu trúc corundum của nhôm ôxít nó còn tạo ra màu cho các đá ruby (đỏ) và emerald (xanh lục).
Ngọc lục bảo (emerald thiên nhiên làm thành mặt dây chuyền. Hình chụp từ link này)
Ngoài lề một tí, mỗi loài đều có số lượng nhiễm sắc thể cố định, không cứ phải càng thông minh, to khỏe thì càng nhiều nhiễm sắc thể. Loài người chúng ta có 46 cái (23 cặp, trong đó có một cặp giới tính X-Y) trong mỗi nhân tế bào, trong khi tinh tinh, gorilla hay thỏ, thậm chí khoai tây thì có 48 cái (24 cặp).
Một số con vi khuẩn có tới cả ngàn cái. Củ cải có 18 cái (9 cặp). Ít nhất là kiến nhảy châu Úc có 2 cái. Còn cái con hay đậu lên quả chanh hay các món chua chua mà nội trợ rất ghét lại là bạn thân của các nhà sinh học: ruồi dấm, với bộ nhiễm sắc thể có mỗi 8 cái (4 cặp), vì số lượng vừa phải, lại hay đẻ nhiều, nên dễ đem nghiên cứu di truyền.